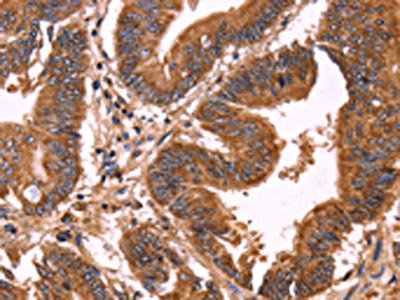

-
中文名稱:ERP29兔多克隆抗體
-
貨號:CSB-PA992687
-
規格:¥1100
-
圖片:
-
The image on the left is immunohistochemistry of paraffin-embedded Human colon cancer tissue using CSB-PA992687(ERP29 Antibody) at dilution 1/40, on the right is treated with synthetic peptide. (Original magnification: ×200)
-
The image on the left is immunohistochemistry of paraffin-embedded Human liver cancer tissue using CSB-PA992687(ERP29 Antibody) at dilution 1/40, on the right is treated with synthetic peptide. (Original magnification: ×200)
-
Gel: 10%SDS-PAGE, Lysate: 40 μg, Lane 1-4: Hela cells, human fetal liver tissue, A549 cells, 293T cells, Primary antibody: CSB-PA992687(ERP29 Antibody) at dilution 1/200, Secondary antibody: Goat anti rabbit IgG at 1/8000 dilution, Exposure time: 40 seconds
-
-
其他:
產品詳情
-
Uniprot No.:
-
基因名:
-
別名:ERP29 antibody; C12orf8 antibody; ERP28Endoplasmic reticulum resident protein 29 antibody; ERp29 antibody; Endoplasmic reticulum resident protein 28 antibody; ERp28 antibody; Endoplasmic reticulum resident protein 31 antibody; ERp31 antibody
-
宿主:Rabbit
-
反應種屬:Human,Mouse,Rat
-
免疫原:Synthetic peptide of Human ERP29
-
免疫原種屬:Homo sapiens (Human)
-
標記方式:Non-conjugated
-
抗體亞型:IgG
-
純化方式:Antigen affinity purification
-
濃度:It differs from different batches. Please contact us to confirm it.
-
保存緩沖液:-20°C, pH7.4 PBS, 0.05% NaN3, 40% Glycerol
-
產品提供形式:Liquid
-
應用范圍:ELISA,WB,IHC
-
推薦稀釋比:
Application Recommended Dilution ELISA 1:2000-1:5000 WB 1:500-1:2000 IHC 1:50-1:200 -
Protocols:
-
儲存條件:Upon receipt, store at -20°C or -80°C. Avoid repeated freeze.
-
貨期:Basically, we can dispatch the products out in 1-3 working days after receiving your orders. Delivery time maybe differs from different purchasing way or location, please kindly consult your local distributors for specific delivery time.
-
用途:For Research Use Only. Not for use in diagnostic or therapeutic procedures.
相關產品
靶點詳情
-
功能:Does not seem to be a disulfide isomerase. Plays an important role in the processing of secretory proteins within the endoplasmic reticulum (ER), possibly by participating in the folding of proteins in the ER.
-
基因功能參考文獻:
- Downregulation of ERp29 was commonly found in GC tissues and highly correlated with more aggressive phenotypes and poorer prognosis. PMID: 28874138
- The anti-aggregation peptide ReACp53 significantly decreased ERP29 expression and suppressed the chemoresistant effect. These findings highlight a role of ERP29 in the acquired chemoresistance of cancer cells expressing the aggregating p53 mutant Arg282Trp. PMID: 28534505
- Results of further analyses by using a CNX mutant imply that ERp29 and ERp57 recognize the same domain of CNX, whereas the mode of interaction with CNX might be somewhat different between them. PMID: 28456374
- High ERP29 expression is associated with pancreatic ductal adenocarcinomas. PMID: 26887611
- our studies prove a novel function of ERp29\MGMT in cancer cell survival against radiation. Targeting ERp29\MGMT axis may be useful for providing better treatment efficacy in combination with radiotherapy in breast cancer. PMID: 26420420
- Endoplasmic reticulum protein 29 attenuates CSE-induced ER stress and enhances cell viability and barrier integrity of RPE cells, and therefore may act as a protective mechanism for RPE survival and activity. PMID: 26431474
- CLIC4, ERp29, and Smac/DIABLO integrated into a novel panel based on cancer stem-like cells in association with metastasis stratify the prognostic risks of colorectal cancer. PMID: 24916695
- overexpression of ERp29 may play a key role in apoptosis in HTR-8/SVneo cells via activation of p38, which may participate in the pathogenesis of intrahepatic cholestasis of pregnancy PMID: 24780196
- ERp29 directs ENaC toward the Golgi, where it undergoes cleavage during its biogenesis and trafficking to the apical membrane. PMID: 24944201
- Apoptosis related proteins ERp29, PRDX6 and MPO were differentially expressed in placentas of pregnant women with intrahepatic cholestasis and in healthy pregnant women. PMID: 24391750
- S1P1 overexpression or ERp29 absence is related to the carcinogenesis and progression, and may be potential biomarkers for early detection of gallbladder adenocarcinoma. PMID: 23558074
- ERp29 is a novel molecule that regulates MET and epithelial cell integrity in breast cancer cells. PMID: 22543584
- Overexpression of ERp29 increases the radioresistance in nasopharyngeal carcinoma. PMID: 21479953
- Suggest that ERp29 associates with radioresistance in nasopharyngeal carcinoma and may be potential biomarker for predicting response to radiotherapy. PMID: 22160175
- Eurycomanone affects the transcription of Erp28, annexin 1 and prohibitin resulting in reduced expression of these proteins. PMID: 21903368
- interplay between p38 phosphorylation and p58(IPK) upregulation has key roles in modulating ERp29-induced cell-growth arrest and survival PMID: 22064321
- ERp29 is a 4PBA-regulated ER chaperone that regulates WT-CFTR biogenesis and can promote DeltaF508-CFTR trafficking in CF epithelial cells PMID: 21525008
- Results identify ERp29 as a novel regulator of PERK and provide evidence for the role of ER resident factors in the regulation of chemotherapeutic efficacy. PMID: 21419175
- High expression of ERp29 inversely correlates to tumor progression. PMID: 20920593
- Expression and tissue distribution of ERp29 [review] PMID: 12362325
- ERp29 is an unusual redox-inactive member of the thioredoxin family [review] PMID: 16677078
- ERP29 is expressed in a subset of basal-cell carcinoma of the skin, with the infiltrating carcinomas exhibiting the highest incidence of immunopositivity. PMID: 17012915
- Results found that ERp29 comprises significant alpha-helical structure. PMID: 17073718
- mutants of the D-domain of ERp29 prevent transport of a substrate protein (Pipe) in a manner consistent with the presence of a discrete, conserved peptide binding site in the D-domain PMID: 17296603
- ERp29-activated polyomavirus perforates the physiologically relevant ER membrane, an event that likely initiates viral penetration. PMID: 17881435
- lactating mammary glands were expressing ERp29 while the resting glands did not PMID: 18395818
- there are two putative peptide binding sites of ERp29 and different processing activity of the human and Drosophila proteins in vivo does not stem from differences in peptide binding properties. PMID: 19084538
- The level of ER protein 29 (ERp29) was shown to be decreased in the CK19-expressing BT549 breast cancer cell line. PMID: 19265690
- This supports a new role for ERp29 as a chaperone that helps stabilize monomeric Cx43 to enable oligomerization to occur in the Golgi apparatus. PMID: 19321666
- ERp29 is a novel regulator leading to cell growth arrest and cell transition from a proliferative to a quiescent state. PMID: 19770839
顯示更多
收起更多
-
亞細胞定位:Endoplasmic reticulum lumen. Melanosome. Note=Identified by mass spectrometry in melanosome fractions from stage I to stage IV.
-
組織特異性:Ubiquitous. Mostly expressed in secretory tissues.
-
數據庫鏈接:
Most popular with customers
-
-
Phospho-YAP1 (S127) Recombinant Monoclonal Antibody
Applications: ELISA, WB, IHC
Species Reactivity: Human
-
-
-
-
-
-